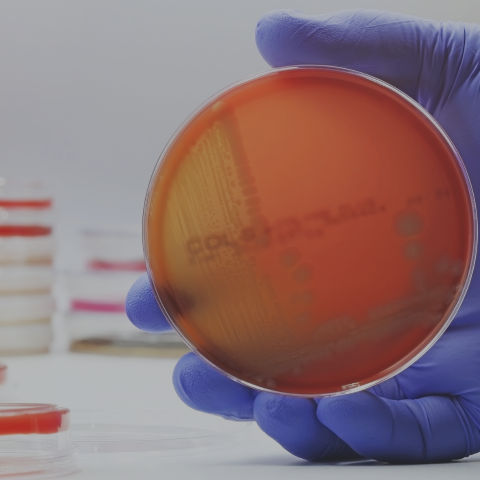

Noticias y Proyectos Destacados

Control de Calidad y Seguridad Alimentaria
2024-10-25
El reciente brote de Escherichia Coli asociado a la conocida hamburguesa Cuarto de Libra de Mc Donald’s, en Estados Unidos, pone en evidencia la necesidad de no solo contar con controles rigurosos en la producción de alimentos, sino que también de verificar que estos se cumplan a cabalidad.
De acuerdo a lo reportado por Centro para el Control y la Prevención de Enfermedades (CDC, por su sigla en inglés), todos los afectados por este brote afirmaron haber comido esa hamburguesa antes de enfermarse, sumando un total de 49 personas infectadas y una fallecida, en diez estados.
Considerando estos antecedentes, se hace fácil dimensionar el tremendo impacto que puede tener no cumplir con los protocolos que buscan asegurar la calidad alimentaria. Para desarrollar más este tema, hablamos con nuestro experto Juan Pablo Molineiro, Gerente de unidad Fisicoquímica y Microbiología de Dictuc.
¿Cómo se contagia la Escherichia Coli?
La Escherichia coli (E. coli) se contagia principalmente a través de:
Consumo de alimentos o agua contaminados: Esto incluye carne cruda o mal cocida, productos lácteos no pasteurizados, y frutas y verduras que han estado en contacto con heces contaminadas.
Contacto directo con personas infectadas: La bacteria puede propagarse si no se siguen adecuadas medidas de higiene, como lavarse las manos después de ir al baño o antes de manipular alimentos.
Contacto con animales infectados o sus entornos: Esto puede ocurrir en granjas, zoológicos, o al manipular animales domésticos sin las precauciones adecuadas.
¿Cuáles son los síntomas asociados a esta enfermedad?
Los síntomas de una infección por Escherichia coli (E. coli) pueden variar, pero los más comunes incluyen:
Diarrea: Puede ser acuosa y, en algunos casos, contener sangre
Dolor abdominal o cólicos: Estos pueden ser bastante intensos.
Náuseas y vómitos.
Fiebre: Generalmente baja, pero puede estar presente.
Cansancio y debilidad.
Estos síntomas suelen aparecer entre 3 y 4 días después de la exposición a la bacteria. En casos más graves, la infección puede llevar a complicaciones como el síndrome urémico hemolítico, que puede causar insuficiencia renal.
¿Cuáles son los protocolos que existen en Chile para asegurar la calidad y seguridad alimentaria?
En Chile el REGLAMENTO SANITARIO DE LOS ALIMENTOS DTO. N° 977/96 (D.OF. 13.05.97) es el marco regulatorio que establece deberes y requisitos en la elaboración, manipulación, distribución y venta de alimentos. Dentro de los aspectos más importantes se encuentran las evaluaciones microbiológicas para productos terminados, manipuladores, superficies, ambientes etc. Con particular atención en patógenos como la E. Coli.
En esta misma línea, el Ministerio de Salud, junto con otros organismos ponen a disposición varias directrices, programas y listas de verificación, orientados a la Calidad Alimentaria, con el objetivo de minimizar el riesgo asociado a intoxicaciones alimentarias producto de ingesta de alimentos en mal estado o mal elaborados.
Pero sin duda, la autoevaluación, monitoreo y seguimiento que realizan las propias empresas o centros elaboradores de alimentos, es fundamental para garantizar la salud de consumidores y clientes.
¿Otro aspecto para destacar o abordar?
Para prevenir una infección por Escherichia coli (E. coli), es fundamental seguir algunas prácticas de higiene y seguridad alimentaria:
Cocinar bien los alimentos: Asegúrate de que la carne, especialmente la carne molida, esté completamente cocida a una temperatura interna segura.
Evitar productos lácteos no pasteurizados: No consumas leche cruda ni productos derivados de ella.
Lavar frutas y verduras: Lava bien las frutas y verduras antes de consumirlas.
Beber agua tratada: Asegúrate de que el agua potable esté adecuadamente tratada y evita beber agua de fuentes no seguras.
Practicar buena higiene personal: Lávate las manos con frecuencia, especialmente después de ir al baño, antes de preparar alimentos y después de tocar animales
Este incidente subraya la importancia de la seguridad alimentaria, no solo para proteger la salud de los consumidores, sino también para asegurar la sostenibilidad de los negocios. En Dictuc, nuestra Unidad de Fisicoquímica y Microbiología trabaja intensamente para apoyar a las empresas en la implementación de protocolos de control que previenen este tipo de riesgos.
Consulta con nuestros expertos: alimentos@dictuc.cl